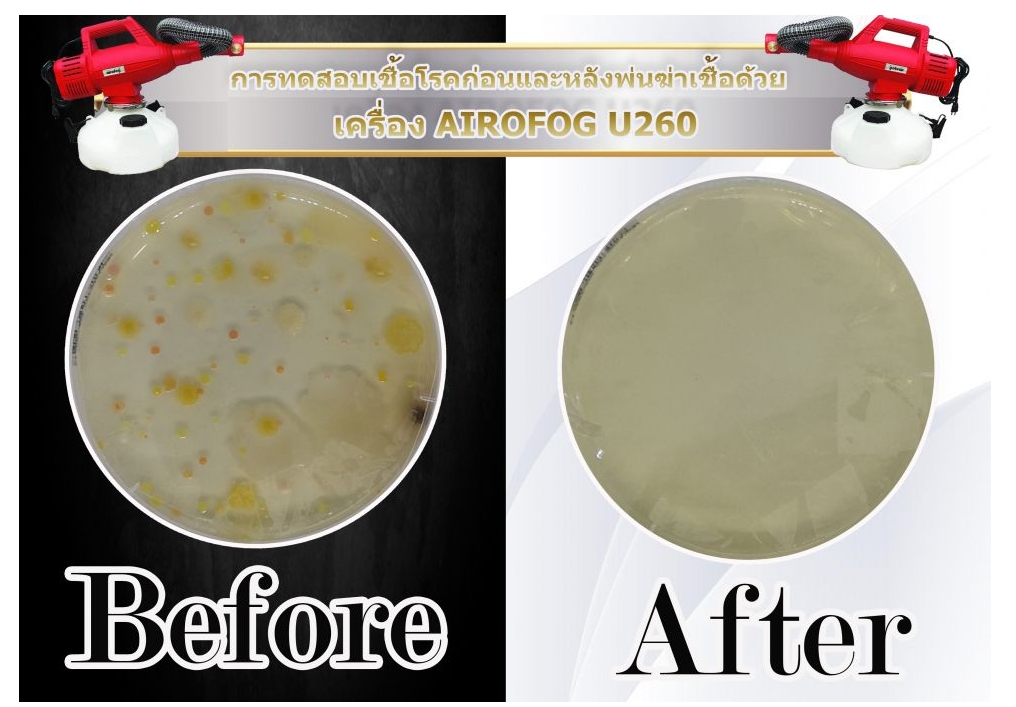
บริการพ่นฆ่าเชื้อ

Our disinfection service guarantees 99.99% elimination of germs.
Our disinfection service is certified and tested by the Department of Medical Sciences, Ministry of Public Health, confirming its effectiveness in eliminating up to 99.99% of viruses, bacteria, and fungi. Using ULV (Ultra Low Volume) fogging technology, we cover every corner of the area. We offer both virus disinfection and commercial disinfection services for residences, office buildings, factories, and other locations, with convenient and fast service options available. Furthermore, our professional team is trained and uses standard equipment to ensure the highest quality disinfection for both residential and commercial settings. Ideal for those seeking peace of mind regarding hygiene, our hi-home style service prioritizes comfort and safety for every family.
Disinfection spraying service. Kills all strains of viruses, including COVID-19, RSV, hand, foot and mouth disease, and H1N1.
Our disinfection service eliminates Coronavirus COVID-19 and SARS-Cov-2 within 1 minute, providing surface protection for up to 14 days. Our professional team is ready to provide disinfection and sanitization services across all areas, including buildings, offices, residences, factories, and general locations. We are a trusted disinfection company for both government and private sectors, using COVID-19 disinfectants containing active ingredients recommended by the WHO (World Health Organization) and public health authorities in Singapore and the United States for their effective elimination of the virus. Importantly, our disinfectants are safe for humans and pets, ensuring you receive the highest quality, standards, and safety when you choose us.
Free gift included!


Interested in inquiring or booking our services?


Effectively protect the area from germs.
Our COVID-19 disinfection service not only helps reduce the risk of viruses and bacteria but also provides peace of mind for everyone in the area. We use highly effective disinfectants, certified safe by leading public health agencies and free from harmful chemicals.
Plan the disinfection schedule to suit the area.
We have a team of professionals ready to provide consultation and planning for disinfection services tailored to each location, ensuring thorough germ elimination in every nook and cranny. Our team is trained in safety procedures and has experience serving high-risk areas such as:- Schools,
- hospitals,
- shopping malls,
- airports,
- office buildings,
- and public places.
Flexible services to meet all your needs.
To provide maximum convenience for our customers, we offer flexible services with appointments available every day to suit your needs. Whether you require a one-time disinfection service or a monthly plan, we are ready to keep your area clean, safe, and germ-free at all times.
Disinfection services for high-risk areas to ensure everyone's safety.
Our disinfection service for high-risk areas ensures everyone's safety, using hospital-grade standards from World Health Disinfection. We utilize CHEMGENE HLD4H medical-grade disinfectant, certified by Mahidol University and NHS England (UK), which kills viruses and bacteria within 1 minute. It's safe and provides long-lasting surface protection. Our professional team uses ULV fogging equipment for thorough coverage. Ideal for hospitals, airports, office buildings, and all types of public spaces.

School disinfection service, medical grade, to control and prevent the spread of viruses and bacteria in classrooms and shared areas. Using CHEMGENE HLD4H disinfectant, which kills germs within 1 minute, it's safe for children and teachers, ensuring clean and safe classrooms every day.

Hospital disinfection service, international standards, safe for patients and medical personnel. Using medical-grade disinfectant CHEMGENE HLD4H, certified by Mahidol University and NHS England (UK), kills viruses within 1 minute with no residue.

Disinfection service for shopping malls, hospital-grade standard, using medical-grade disinfectant CHEMGENE HLD4H, certified by Mahidol University and NHS England (UK). Safe for shoppers and staff.

Airport disinfection service, meeting international standards from World Health Disinfection. We use medical-grade disinfectant CHEMGENE HLD4H, certified by Mahidol University and NHS England (UK), ensuring safety for passengers and staff.

We offer disinfection services for office buildings and public places using CHEMGENE HLD4H medical-grade disinfectant, certified by Mahidol University and NHS England (UK). It is safe for users and eliminates viruses within 1 minute.

Disinfecting the airport.

Disinfecting Busarakam Hospital, Ministry of Public Health.

Disinfecting the Parliament building.

COVID-19 disinfection service using Chemgene by Byotrol disinfectant.
Europe's #1 high-efficiency disinfectant product effectively eliminates viruses. We also offer disinfection services using state-of-the-art, safe
and internationally standardized ULV sprayers, ensuring peace of mind in protecting any area you wish to protect.


Byotrol is a multinational market leader in biocidal technology, based in the UK, specializing in the development of a wide range of antimicrobial products.

MEDIMARK SCIENTIFIC is a manufacturer of advanced infection control and biosafety products for industry, human health, animal health, life sciences, and the environment.

Blutest results show effectiveness against enveloped viruses, including Coronavirus, at a 1:10 dilution under a 5-minute contact time.

Test results from Chemila show that the product can reduce the number of particles infected with the vaccinia virus under specified conditions (EN 14476:2013 +A2:2019, 10%, 30 minutes, clean conditions, 20°C).
Why choose our disinfection service?
Thailand's No. 1 leader in disinfection services.
We provide comprehensive disinfection services using a variety of fogging machines, suitable for all locations including residences, offices, factories, schools, and high-risk areas nationwide.
High-quality nebulizer, hospital standard.
We use the latest ULV (Ultra Low Volume) fogging machines, which are clean, safe, and stable. We also provide maintenance and spare parts directly from the importer, ensuring readiness for use in all situations.
Professional team with over 5 years of experience.
Our team is specially trained, has over 5 years of experience in disinfection services, and uses state-of-the-art equipment on par with that used by leading airlines and hospitals.
We cover the area and provide services at times that are convenient for customers.
We offer flexible service, with appointments available every day, and provide professional security in all areas.
Our disinfection spraying service is certified by numerous organizations.
Customers can therefore be confident in the quality and service.

CHEMGENE HLD4H is an extra-concentrated disinfectant solution manufactured and imported from the UK. It effectively kills a wide range of germs, bacteria, fungi, and viruses. CHEMGENE HLD4H contains chemicals capable of eliminating the coronavirus, such as Benzalkonium Chloride and Didecyldimethylammonium Chloride, which are certified by the Environmental Protection Agency (EPA) and the National Environment Agency (NEA).
ULV (Ultra Low Volume) foggers are developed specifically for spraying disinfectants into the air. They release fine mist particles that float in the air to thoroughly eliminate pathogens. They are ideal for post-infection disinfection and controlling the spread of airborne pathogens such as COVID-19, influenza, RSV, H1N1, H5N1, as well as various fungi and bacteria.
The fogging machine has been approved by the Department of Medical Sciences, Ministry of Public Health.
We are the only company in Thailand that uses fogging machines that have been tested and certified by the Department of Medical Sciences, Ministry of Public Health. You can be confident that every machine meets the highest standards of efficiency and safety, ensuring thorough and effective disinfection of air and surfaces. Our services include COVID fumigation, COVID spraying, and COVID disinfection in various areas such as residences, office buildings, schools, factories, and public places. We also offer disinfection fumigation services designed for maximum effectiveness in eliminating viruses and bacteria, providing peace of mind for every family and organization.


Watch the video review! Disinfection spraying in real-world operation at Government House.
Watch our video review of a real-world disinfection process at Government House, using a German-made ULV machine and CHEMGENE hospital-grade disinfectant, which kills 99.99% of viruses. This effectiveness is guaranteed by national-level agencies. Our professional team has extensive experience disinfecting important locations including government agencies, hospitals, and high-risk areas, ensuring safety at every step. We also offer disinfectant cleaning services and office disinfection, suitable for office buildings, factories, and businesses requiring the highest level of hygiene and safety to build confidence among employees, customers, and visitors.
Steps for booking and receiving disinfection services.
Our disinfection service is conducted in five simple steps: booking an appointment, site preparation, staff deployment, a 30-minute wait, and immediate access to the area. All steps are safe, effective, and overseen by a team of professionals.
 |  |  |  |  |
| Book an appointment with an officer. | Prepare the venue. | Officials are spraying disinfectant. | Please wait 30 minutes. | Access as normal. |
Customers can submit insurance claims in company format using the receipt.
We can issue a tax invoice and deduct 3% (withholding tax). Customers who use our services will receive a free spray bottle and wet tissues.
Thank you to our customers for trusting us with your virus and germ disinfection cleaning service.
Many clients trust our cleaning and virus disinfection services, including key organizations like the Prime Minister's Office and Busarakham Hospital, as well as leading companies such as Shopee, Krung Thai Bank, and Thai Airways. This trust reflects the quality and safety of our services. Our professional team and state-of-the-art equipment ensure every disinfection task is efficient, clean, and safe. We offer professional disinfection services emphasizing international standards, and comprehensive sanitization services for residences, office buildings, factories, and businesses, giving clients confidence that all areas are truly clean, safe, and germ-free.

Office of the Prime Minister and the COVID-19 Situation Management Cente

Office of the Prime Minister and the COVID-19 Situation Management Cente

Shopee (Thailand) Co., Ltd.

Disinfecting entertainment venues.

พ่นฆ่าเชื้อสายการบิน

Disinfecting the school with spraying disinfectant.

Disinfecting British Columbia International School.

Disinfecting Krung Thai Bank.

Spray disinfectant in the children's play area.
Lorem ipsum dolor sit amet, pri et feugiat consulatu. Eu per ceteros platonem. Ea dictas legendos ius. At adhuc solum has. Nec at harum euripidis, habeo elitr patrioque ne mel. Mei probo oportere posidonium in, has ei everti volutpat consequat.

Thai Airways disinfection service.

Bangkok Aviation Disinfection Service

Disinfection service for NokScoot airline.

Disinfecting electric cars.

Disinfecting the airplane passenger cabin.

Disinfect cabin luggage with a spray.
Our COVID-19 disinfection service uses high-quality, internationally certified disinfectants that effectively eliminate viruses, bacteria, and fungi. It's safe for people and pets, and environmentally friendly. Our professional team provides disinfection services in various locations such as homes, offices, shops, factories, and public areas, using modern ULV fogging equipment to cover all high-risk areas. We also sell a variety of disinfectants, including COVID-19 disinfectants, fungicides, and general disinfectants, suitable for use in hospitals, schools, restaurants, and other establishments to reduce the risk of infection. Our disinfection service prioritizes quality, safety, and peace of mind. With over 5 years of experience, we offer professional consultation on disease control and hygiene in all areas.
Interested in inquiring or booking our services?

Powered by
MakeWebEasy.com













